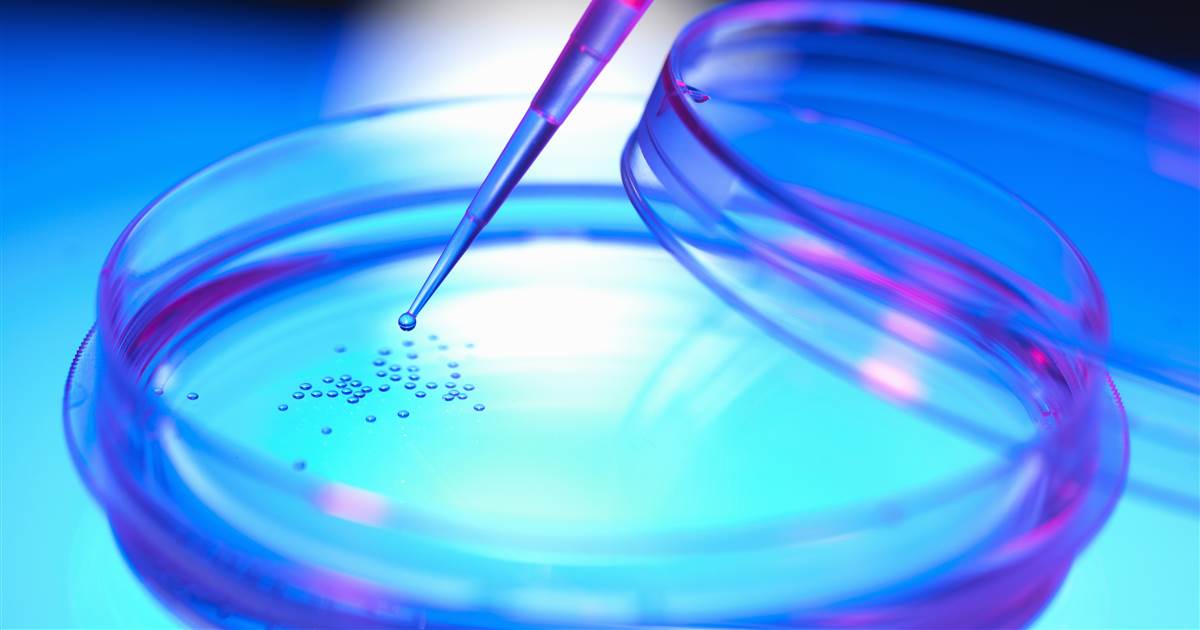

Guide To Understanding Stem Cells
All of the cells in an individual's body have a specific purpose once they have matured and differentiated into different types of tissues in different locations. Stem cells serve as the blank template for cells, as they are undifferentiated until they are needed for a specific tissue in the body. Stem cells can divide into other stem cells as well as the ability to become differentiated cells like brain, blood, and muscle cells. In tissues with regeneration benefits, stem cells are imperative because they replace dead cells. Stem cells are present in the brain, blood vessels, skin, gut, teeth, liver, bone marrow, skeletal muscle, teeth, liver, and other organs. Stem cells are also present within the fluid that surrounds a fetus in an amniotic sac. Stem cells are beneficial to help researchers understand more about how an organism forms from one cell and how defective cells are replaced by healthy cells in animals and humans.
Get the facts on stem cells now.
Types Of Stem Cells

There are two primary classifications for stem cells: embryonic stem cells and adult stem cells. Embryonic stem cells are taken from unused embryos resulting from in vitro fertilization that have been donated to science. Embryonic stem cells can differentiate into any type of cell, or are considered pluripotent. Adult stem cells are further categorized into stem cells found in an individual's fully developed tissues and induced pluripotent stem cells. Adult stem cells found in the brain, bone marrow, and skin tissues that are fully developed are not abundant in the body. These stem cells tend to only differentiate into cells that are part of the same type of tissues that make up the organ they came from. Induced pluripotent stem cells are a form of adult stem cells that have been sent to a laboratory environment where they have been changed, altered, or manipulated to take on the same properties and characteristics of embryonic stem cells. Pluripotent adult stem cells have been reprogrammed to function the same way as embryonic stem cells.
Get familiar with the sources of stem cells next.
Sources Of Stem Cells

Several dependable sources of stem cells are utilized in medicine today. One of the most useful sources of stem cells discovered to date is those found in umbilical cord blood discarded as human waste. Blood stem cells or hematopoietic stem cells are abundant in umbilical cord blood and are easy to collect. Another source used when the umbilical cord blood is not accessible is stem cells in the bone marrow. This source of stem cells can be costly because it requires a procedure for the donor collection of the bone marrow, as well as for the individual receiving the stem cells. While the process of using stem cells taken from bone marrow is not easy or convenient, its benefits do outweigh its difficulties. The recent discovery of stem cells in human teeth has led to using the teeth as a source for specialized stem cells referred to as mesenchymal stem cells. Mesenchymal stem cells are not limited to what type of cell they can differentiate into and may give rise to any type of cell found in the body. The extraction process of stem cells from teeth is easy and the most cost-effective way to obtain mesenchymal stem cells.
Uncover information about uses for stem cells now.
Uses For Stem Cells

Stem cells have many uses in medicine today. They are often used in research that looks into how an organism forms from one single cell and how healthy cells end up replacing defective cells. Stem cells have helped with research into different types of treatments and medications by providing insight into how these forms of treatment affect the cells. This type of research has helped the medical community understand cancerous cells better and has provided help in the development of anti-cancer drugs. Stem cells are also used to gain an understanding of how to treat diseases caused by the lack of cell regeneration in certain tissues like diabetes and heart disease. Stem cells are not only extremely useful to medical research, but are also being used to treat cancers of the blood, diseases and cancers of the immune system, and bone fracture defects. Individuals affected by disorders and diseases that destroy the bone marrow tissues or blood cells can replace the dead and diseased bone marrow with the use of a stem cell transplant.
Learn about stem cell donation next.
Stem Cell Donation

Thousands of individuals in the United States are diagnosed with life-threatening diseases, like lymphoma and leukemia, every year. For many of these individuals, stem cell transplants are the only hope for curative treatment. Just like donor organs are needed for organ transplant recipients, stem cells are also needed for recipients. For a long time, donor stem cells could only be obtained by the use of a painful and expensive procedure to draw the bone marrow stem cells directly out of the donor's bone. However, advances in research and technology have made it possible for stem cells to be collected from a donor's blood. This method is referred to as peripheral blood stem cell donation. The risks of peripheral stem cell donation are very minimal in comparison to the risks associated with a traditional bone marrow stem cell collection procedure. A traditional bone marrow stem cell collection procedure requires the use of anesthesia, which has several risks in itself. Recovery from a traditional collection procedure takes several days and can be relatively painful. The risks of peripheral stem cell donation are similar to those of a traditional blood donation.
Learn about the controversy surrounding stem cells next.
Stem Cell Controversy
From the time stem cells were first brought to the public eye in the late 1990s, the use of stem cells for medical research has been surrounded by controversy. Because stem cells were being taken from human embryos to perform research, conflict arose because this required the destruction of an embryo. As the population has widely differing beliefs surrounding what they consider to be the start of human life, the destruction of embryos for medical research purposes has created complex issues. Some individuals feel human life begins at birth, while others believe human life begins at the moment of conception. Many individuals believe human life begins at a point somewhere between conception and birth. Because legislation determines what funds are used for research, the study of stem cells from embryos has become a major political issue and argument. The discovery and use of adult pluripotent stem cells have helped alleviate some tension regarding this subject, but moral and ethical conflict still surrounds stem cell research.